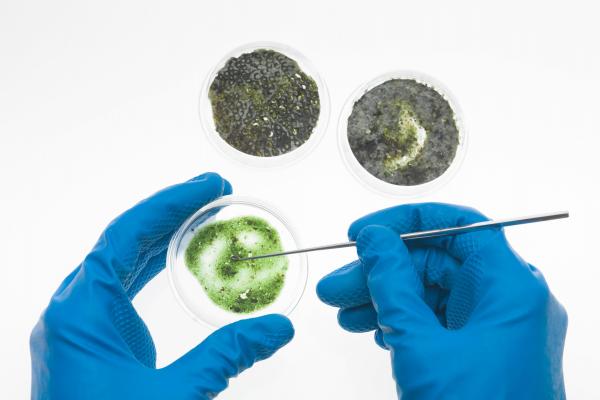

Máster universitario en Genética, Física y Química Forense
-
La universidad es muy buena y potente, el profesorado es muy bueno, nos hacen trabajar mucho
← | →
-
La universidad esta muy bien en cuanto a estructura y servicios administrativos. Si eres un estudiante extranjero también tienen un departamento que te ayuda a gestionar todo el papeleo para que puedas solicitar una visa de estudios en tu país de origen.
← | →
-
El Máster universitario en Genética, Física y Química Forense está de lo mejor debido al nivel que tienen los docentes que imparten cada clase del máster. A nivel de infraestructura la universidad debería invertir más capital para darle ese toque de modernidad.
← | →
Master oficial
En Tarragona

¿Necesitas un coach de formación?
Te ayudará a comparar y elegir el mejor curso para ti y a financiar tu matrícula en cómodos plazos.
¡Marca la diferencia a partir de tus conocimientos y proyecta tu futuro!
-
Tipología
Master oficial
-
Modalidad horaria
Part time / Full time
-
Idiomas
Català, Castellano
-
Lugar
Tarragona
-
Duración
2 Cuatrimestres
-
Inicio
Octubre 2026
-
Créditos
60
Cuánto no has esperado por una formación actual para poder conocer el mundo forense. El Máster Universitario en Genética, Física y Química Forense que te presenta Emagister y es impartido por la Universitat Rovira i Virgili, es la oportunidad ideal de lograr tus sueños y alcanzar tus metas profesionales.
Con este máster adquirirás una formación científica multidisciplinaria avanzada en el campo de la práctica forense en los ámbitos de la química, la física, la genética o la estadística, de manera que adquieras una formación especializada en un amplio abanico de disciplinas científicas que intervienen en los análisis científicos de evidencias de la escena de un crimen, o hechos y circunstancias relacionadas con un procedimiento judicial, con la finalidad de que puedas formar parte de equipos interdisciplinarios en tu futuro profesional.
Si estás interesado en cursar esta formación, haz clic en “Pedir información”, de esta forma nuestros asesores podrán ponerse en contacto contigo para proporcionarte toda la información que necesitas y resolver todas las dudas que tengas. ¡No dejes pasar esta gran oportunidad!
Información importante
Para realizar esta formación debes tener uno de estos niveles de estudios: Grado, Licenciatura, Diplomatura, Máster, Posgrado, Doctorado
Orientación profesional
Instalaciones y fechas
Ubicación
Inicio
Inicio
A tener en cuenta
- Proporcionar formación científica multidisciplinaria avanzada en el campo de la práctica forense en los ámbitos de la química, la física, la genética o la estadística, de manera que adquieras una formación especializada en un amplio abanico de disciplinas científicas que intervienen en los análisis científicos de evidencias de la escena de un crimen, o hechos y circunstancias relacionadas con un procedimiento judicial, con la finalidad de que puedas formar parte de equipos interdisciplinarios en tu futuro profesional.
- Desarrollar las capacidades necesarias para la interpretación de evidencias en la escena de un crimen a partir del conocimiento de los fundamentos químicos, físicos y biológicos de las principales técnicas de análisis forense.
- Formar profesionalmente con las competencias necesarias para hacer evaluaciones, informes o peritajes para que puedas aportar tus conocimientos en laboratorios destinados al estudio de problemas relacionados con la práctica forense, tanto en organismos públicos como privados.
El Máster está dirigido a titulados universitarios con formación en ciencias experimentales, ciencias de la vida y tecnologías afines, como grados en Bioquímica, Biología, Química, Biotecnología, Física, Geología, Medicina, Veterinaria, Farmacia, Ciencias Ambientales, Ciencia y Tecnología de los Alimentos, o en Ingenierías Técnicas y diplomaturas en ámbitos científicos. También está dirigido a profesionales forenses que deseen profundizar en algún aspecto concreto.
Además de la documentación general obligatoria para realizar la preinscripción, es necesario presentar una carta de motivación dirigida a la coordinación académica, así como acreditación de los méritos incluídos en el currículum vitae.
Opcionalmente también se puede acreditar formación complementaria relacionada con el contenido del máster y del conocimiento y nivel de lenguas diferentes al español (nivel B2), de acuerdo con el Marco Europeo Común de Referencia para las Lenguas.
Opiniones
-
La universidad es muy buena y potente, el profesorado es muy bueno, nos hacen trabajar mucho
← | →
-
La universidad esta muy bien en cuanto a estructura y servicios administrativos. Si eres un estudiante extranjero también tienen un departamento que te ayuda a gestionar todo el papeleo para que puedas solicitar una visa de estudios en tu país de origen.
← | →
-
El Máster universitario en Genética, Física y Química Forense está de lo mejor debido al nivel que tienen los docentes que imparten cada clase del máster. A nivel de infraestructura la universidad debería invertir más capital para darle ese toque de modernidad.
← | →
Valoración del curso
Lo recomiendan
Valoración del Centro
Josep Bargues
Opinión verificadaNerea
María
Logros de este Centro
Todos los cursos están actualizados
La valoración media es superior a 3,7
Más de 50 opiniones en los últimos 12 meses
Este centro lleva 19 años en Emagister.
Materias
- Bioquímica
- Genética
- Biomedicina
- Análisis forense
- Ciencias ambientales
- Física y química
- Biología
- Química
- Física y Química Forense
- Técnicas Cromatográficas en Análisis Forense
- Genética forense
- Química forense
- Análisis de Datos Químicos
- Análisis de Casos Forenses
- Técnicas cromatográficas
- Introducción a las Ciencias Forenses
- Ciencia
- Ciencias forenses
Profesores

Dr. Raul Beltrán
Coordinador académico
Es profesor visitante de Bioquímica y Biología Molecular del Departamento de Bioquímica i Biotecnologia de la Universitat Rovira i Virgili. Es miembro del grupo de invesstigación "Bioactividad Molecular de los Alimentos". Ha publicado 80 artículos en revistas internacionales indexadas.
Temario
Plan de estudio: 60 ECTS de asignaturas obligatorias, incluyendo el Trabajo de Fin de Máster de 18 ECTS
Asignaturas anuales
- Genética Forense
- Química Forense
Asignaturas primer cuatrimestre
- Física Forense
- Introducción a las Ciencias Forenses
- Técnicas Cromatográficas en el Análisis Forense
Asignaturas segundo cuatrimestre
- Análisis de Datos Químicos de Interés Forense
- Análisis de Casos Forenses
- Trabajo de Fin de Máster
¿Necesitas un coach de formación?
Te ayudará a comparar y elegir el mejor curso para ti y a financiar tu matrícula en cómodos plazos.
Máster universitario en Genética, Física y Química Forense